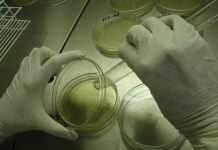
Bakterije, ki so genetsko blizu ljudem, nosijo veliko skrivnost An detail of a analyst pouring some medium for a bacteria culture essay inside a petri dish inside a sterile environment with laminar flow hood

Ekipa znanstvenikov pod vodstvom Britancev bo z uporabo rentgenske tehnologije razkrila 200 let stare skrivnosti otroških mumij iz kapucinskih katakomb v Palermu na severu Sicilije, piše The Guardian.
Dr. Kirsty Squires z univerze v Staffordshiru bo vodila prvi poskus pripovedovanja zgodb nekaterih od 163 otrok, katerih posmrtni ostanki ležijo v hodnikih in kriptah znamenite podzemne grobnice.
Katakombe vsebujejo 1284 mumificiranih in okostenelih teles, kar je največja zbirka mumij v Evropi. Mnogi od tamkajšnjih otrok so zdaj okosteneli, za druge pa je bilo opisano, da so videti, kot da spijo.
Dvoletna preiskava se bo osredotočila na otroke, ki so umrli med letoma 1787 in 1880, sprva pa na 41 trupel, ki so bila shranjena v prilagojeni otroški kapeli.
Identiteta, vzrok smrti in zdravstvena zgodovina otrok niso znani, opisne oznake na njih pa so že zdavnaj zbledele.
Upajo, da bo s primerjavo anatomskih izsledkov z arhivskimi zapisi, vključno z dvema knjigama, ki vsebujeta imena in letnice smrti, mogoče dobiti boljšo sliko o življenju in smrti otrok.
Opravili bodo terensko raziskavo
»Januarja bomo opravili terensko delo,« je dejala Squires. »S seboj bomo vzeli prenosno rentgensko napravo in naredili na stotine posnetkov otrok z različnih zornih kotov. Upamo, da bomo bolje razumeli njihov razvoj, zdravje in identiteto, pri čemer bomo biološke najdbe primerjali z bolj kulturnimi stvarmi: načinom, kako so bili posamezniki mumificirani, in tudi oblačili, ki so jih nosili.«
Katakombe, ki so bile nekoč namenjene le umrlim bratom kapucinskega reda, so postale priljubljena, čeprav grozljiva turistična atrakcija, saj so v vsaki niši in razpoki na ogled trupla. Ohranjeni mrtvi so bili pogosto oblečeni v svoja najlepša oblačila, obiskali pa so jih tudi njihovi sorodniki.
Bratje so se prvič naselili v cerkvi Santa Maria della Pace leta 1534. Za svoje umrle so ustvarili množični grob, ki se je pod oltarjem odpiral kot cisterna, ko pa se je ta napolnil, so umrle shranili v trezor ali kostnico, medtem ko so kopali novo grobnico.
Ko je bilo treba premestiti trupla iz prepolne grobnice, so ugotovili, da je bilo 45 umrlih bratov ekshumiranih naravno mumificiranih in da so bili njihovi obrazi prepoznavni, kar so imeli za božjo uslugo.
Namesto da bi posmrtne ostanke pokopali, so jih razstavili kot relikvije v nišah ob stenah prvega hodnika novega pokopališča. Leta 1787 je bilo objavljeno pismo, v katerem je bilo navedeno, da imajo vsi prebivalci regije, tudi otroci, pravico do posmrtne namestitve v katakombah.
Malo raziskav se je nanašalo na mumije otrok
Skoraj vse dosedanje raziskave so se nanašale na mumije odraslih, razen raziskave Rosalie Lombardo, ki je 6. decembra 1920, teden dni pred svojim drugim rojstnim dnem, umrla zaradi pljučnice.
Dr. Dario Piombino-Mascali, ki pri najnovejšem projektu v katakombah sodeluje s Squiresovo, je pred desetletjem raziskal njeno presenetljivo popolno ohranjenost.
Povedal je: »Veliko mumij je posledica naravne dehidracije. Druge mumije so bile kemično obdelane. Kemično obdelane so običajno bolje ohranjene. Nekatere so odlično ohranjene. Nekatere so res videti kot speči otroci. Sčasoma so potemnele, nekatere pa imajo celo umetne oči, tako da se zdi, da vas gledajo. Videti so kot majhne punčke. Seveda si želite narediti nekaj, da bi jih ohranili in poskrbeli, da se njihove zgodbe pripovedujejo in da dajejo občutek, da so to otroci. Ko imaš v antropologiji opravka z otroki, je to zelo neprijetno«.
Rentgenske posnetke – 14 na mumijo, od glave do pet – bo naredil in pregledal doktor Robert Loynes, upokojeni ortopedski kirurg, ki je pred tem raziskoval staroegipčanske mumije. Piombino-Mascali je dejal, da je bistveno, da je delo na krhkih truplih neinvazivno.
Slike bo narisal umetnik Eduardo Hernandez iz Los Angelesa, ki bo izdelal ilustracije za izobraževalne letake, ki se bodo delili v katakombah in drugod. Projekt je prejel več kot 70.000 funtov podpore britanskega Sveta za raziskovanje umetnosti in humanistike (Arts and Humanities Research Council). Zadnja telesa, ki so bila internirana v katakombah, so umrla v začetku 20. stoletja.
Novinar